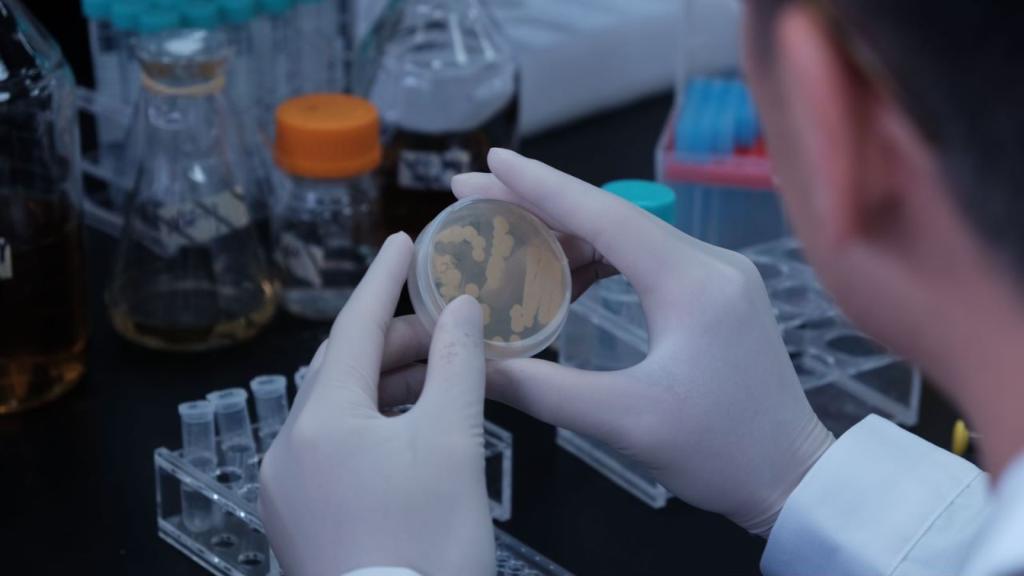

2024-10-26 13:19
你是否好奇,
一块板筋如何从工厂流水线走向你的餐桌?
一条鲟鱼产出“黑珍珠”的背后,
隐藏着多少科研人员的心血?
一株辣椒中又蕴含着怎样的“美味密码”?
……
2024世界农业科技创新大会在北京登场,
看传统农业遇上现代科技
会擦出怎样的火花?
跟随“百闻不如一见”
一起探秘餐桌上的科技“知味”!

一块板筋里的“创新蛋白”
这款由苏陀科技推出的植物基板筋,
不仅味道鲜美、口感更佳,而且不塞牙。
背后依托的是先进的替代蛋白技术。

苏陀科技实验室内两名研究人员正在开展蛋白功能分析实验。受访者供图
“我们从豆类、谷物中提取蛋白,
采取特殊工艺对分子结构展开排列、重塑,
形成大块的植物蛋白肉。”
苏陀科技创始团队成员康定荣介绍。
该公司的植物蛋白产品已实现规模量产,
并且制作出与动物肉结构相似度高的整块蛋白肉。
它们的营养内涵
满足了国民营养健康指导委员会办公室
发布的成年人日均建议摄入量。
苏陀科技实验室内康定荣博士正在观察菌株形态。受访者供图
从植物基手撕肉到植物肉排汉堡,
再到蛋白辣条等创新产品,
从微生物学、食品化学等学科的交叉融合,
到生产设备、产品研发、供应链等
上下游协同创新,
替代蛋白技术为未来食品的发展带来无限可能……

一条鲟鱼里的“黑珍珠”
看着这只鲟鱼,
你能否联想到电影里恐龙在水中游泳的样子?
鲟鱼体型大、寿命长,
是世界上最古老的鱼类之一。
它们产出的鱼子酱被誉为“黑珍珠”,
与鹅肝、松露并称“世界三大珍馐”。
曾经,鱼子酱是昂贵的进口商品,
但如今,中国生产的鱼子酱
已经占据了世界市场的一席之地,
背后离不开中国科学家们的科技创新。

杂交鲟“京龙1号”。新华社记者 任超 摄
“为了让鲟鱼品质更高、怀卵量比例更大,
我们选育新品种,
努力实现鲟鱼养殖优良品种的更新换代。”
北京市农林科学院水产科学研究所研究员胡红霞介绍。
胡红霞团队历时22年,
以西伯利亚鲟欧洲群体为母本,
以施氏鲟黑龙江群体为父本,
对父母本进行连续两代群体选育杂交,
在2021年,培育出了杂交鲟“京龙1号”。
它们具有生长速度快、规格整齐、
养殖成活率高的特点。

杂交鲟“京龙1号”所生产的鱼子酱。受访者供图
培育一个新品种,
按照传统的选育方法需要连续四代选育。
胡红霞团队正在研发鲟鱼全基因组选择育种的液相芯片,
希望通过基因芯片育种的办法,
在两代内完成稳定遗传。
这一创新,将极大地推动鲟鱼育种行业的发展。

一株辣椒中的“植物密码”
你见过像螺丝钉一样螺旋的辣椒吗?
这可不是普通的辣椒,
而是北京市农林科学院蔬菜研究所
副研究员王朝莲团队,
精心培育的螺丝椒“旋美32号”。
它以其鲜艳的颜色、
火辣的味道和绵糯的口感,
成为辣味爱好者的“新宠”。
王朝莲2006年起从事辣椒育种,
她的目标是培育出既抗病又高产,
同时保持原有风味和外观的新品种。

一株株“旋美32号”螺丝椒鳞次栉比在田间排列生长。受访者供图
正常培育一个新品种至少要6到8年时间,
为了提高效率,
她跑到海南进行“加代育种”。
“辣椒的生长周期大约120天,
在北方收完到海南再种,
一年能干两年的活,
4年就能育成一个新品种。”
经过无数次的试验和改良,
王朝莲团队2019年培育出螺丝椒“旋美2号”,
辣椒界的“全螺时代”正式开启。
又经过4年不懈努力,
育种团队通过多次更新迭代,
历经31个版本的升级繁育工作,
最终选育出了适应性广泛、
旋转美观且综合性状优良的“旋美32号”螺丝椒。
它一上市便受到了广泛关注和喜爱
如今,这些辣椒种子不仅遍布中国,
还远销美国、墨西哥等国家。
背后是王朝莲团队一次次技术难题的攻破,
更是新农人对基因奥秘的探索。

温常龙(左一)在实验室讲解分子育种技术。受访者供图
此外,北京市农林科学院蔬菜研究所所长温常龙介绍,
育种团队还利用高通量分子育种技术培育蔬菜新品种,
大大提高了育种效率并加快了育种的进程。
这是对种质资源“卡脖子”问题的有效解决。
一蔬一饭,一餐一饮,
都蕴藏着人类的幸福指数。
“给农业插上科技的翅膀”
“践行大食物观”
“构建多元化食物供给体系”
“农食系统转型”,
越来越多的“中国方案”展现到世界面前,
为人类粮食安全和生命健康作出新的贡献。
新华社记者:丁静、马晓冬、余佩璇、张晨霖、任超、胡傲霜
制作:陆烨